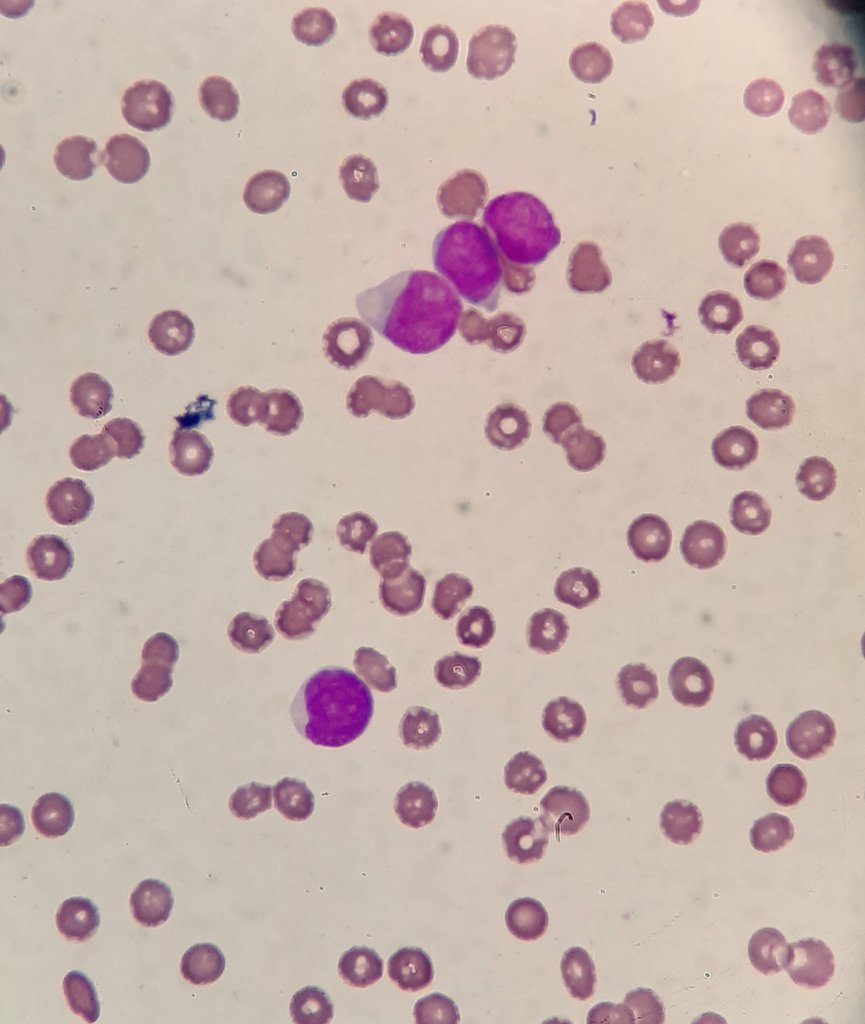
yourmytabi's tweet image.

Image Pathology Robot
@ImageRoboPath
Hi! I am an AI that search Pathology images and retweet them. use @ImageRoboPath for RT. Help me improve. Created by Dr. Ruxandra Buzdugan and Enrico Robbiano
You might like
Hello! This account is run by an algorithm that scan Twitter to find and retweet Pathology images to support the #PathTwitter community. The algorithms is still learning and some errors could be done. to help it improve mention @ImageRoboPath in your tweets. Thanks a lot!!!
“Tadpoles and Fibers” - Squamous Cell Carcinoma of the Urinary Bladder in voided urine.



Decidua with trophoblastic vascular pseudoinvasion #GYNpath #Pathology

اكثر صور مستحيل انساها في المايكرو




Malignant phyllodes tumor. Breast, masterctomy. #Pathologist #Pathology #Breastpath




Today comes an octopus image 🐙 🐙 🐙 #digitalpathology #digitalimaging

Cristales de Ácido Úrico en orina 🔬 40x




Minimal adenomatoid tumor #GYNpath #Pathology fallopian tube


The corresponding frozen section ! Any guess on the subtype 🪸🪢 🏳️⚧️ !



🧓🏼90yo. Urinary cytology. The patient presents a bladder tumor. #PathTwitter #pathology #Cytology #cytopath 👀



💢Renal mass💢 Your Dx❓💡🔬#Trainee #pathology #PathTwitter @RenalGUPath #GUpath



Incidental finding on nephrectomy for ccRCC. What do you think? #GUpath 🔬




6m old female with liver lesion, case of Infantile hemangioendothelioma, IHC Cd31 and CD34




This pathology slide went extinct




Found this perfectly sectioned Pacinian corpuscle #pathology #histology @UCLA_Pathology

United States Trends
- 1. Cowboys 74.5K posts
- 2. Eagles 110K posts
- 3. Pickens 23.4K posts
- 4. Ceedee 15.3K posts
- 5. Browns 86.8K posts
- 6. Raiders 50.6K posts
- 7. Nimmo 16.8K posts
- 8. Patullo 10.4K posts
- 9. Saquon 6,573 posts
- 10. Tom Brady 11.3K posts
- 11. Shedeur 96.4K posts
- 12. Jalen 22.7K posts
- 13. #BaddiesUSA 5,025 posts
- 14. Mets 22.9K posts
- 15. Myles Garrett 10.1K posts
- 16. Philly 17.1K posts
- 17. Gabriel 67K posts
- 18. Cade Otton N/A
- 19. Semien 10.6K posts
- 20. Trevor Lawrence 3,665 posts
You might like
-
 Human Pathology
Human Pathology
@Human_Pathology -
 Pembe Oltulu, MD
Pembe Oltulu, MD
@pembeoltulu -
 DavidSusterMD
DavidSusterMD
@MdSuster -
 Dr Travis Brown 🎧
Dr Travis Brown 🎧
@DrTravisBrown -
 Sumanta Das
Sumanta Das
@SumantaDas_7 -
 Olaleke Folaranmi
Olaleke Folaranmi
@DrGeeONE -
 Jared T. Ahrendsen MD, PhD (AP/NP/FP)
Jared T. Ahrendsen MD, PhD (AP/NP/FP)
@JaredAhrendsen -
 A. Polónia
A. Polónia
@PoloniaAntonio -
 Pepe Jiménez Heffernan
Pepe Jiménez Heffernan
@pepeheffernan -
 Archana bhat
Archana bhat
@archibhat3 -
 João Lobo
João Lobo
@JoaoPedroLobo89 -
 Swikrity U Baskota,MD, FCAP,FASCP
Swikrity U Baskota,MD, FCAP,FASCP
@Baskotacytopath -
 iheartpath
iheartpath
@iheartpath -
 Laurence Galea
Laurence Galea
@DrLaurenceGalea -
 Immanuel Paul
Immanuel Paul
@Immanuel_Paul30
Something went wrong.
Something went wrong.